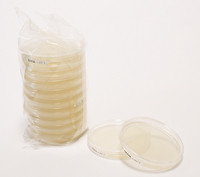
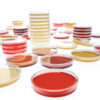

| Tên sản phẩm: | R2A Agar – LI EP 30ml 20PC Merck |
| Tên khác: | Reasoner´s 2A agar |
| Code: | 1460750020 |
| Hãng- Xuất xứ: | Merck- Đức |
| Ứng dụng: |
– Xác định tổng số vi khuẩn trong nước pha tiêm với số lượng lớn, nước tinh khiết cao và nước tinh khiết với số lượng lớn – Dùng trong nuôi cấy và thử nghiệm vi sinh trong phòng thí nghiệm |
| Tính chất: |
– Dạng: rắn – Màu sắc: trắng ngà – Giá trị pH: 7,2 (H₂O) |
| Bảo quản: | Bảo quản ở +15°C đến +25°C |
| Quy cách: | 20 tấm / hộp |
Thông tin đặt hàng:
| Code: | Quy cách |
| 1460750020 | 20 tấm / hộp |
| 1460750120 | 120 tấm / hộp |

Đánh giá
Chưa có đánh giá nào.